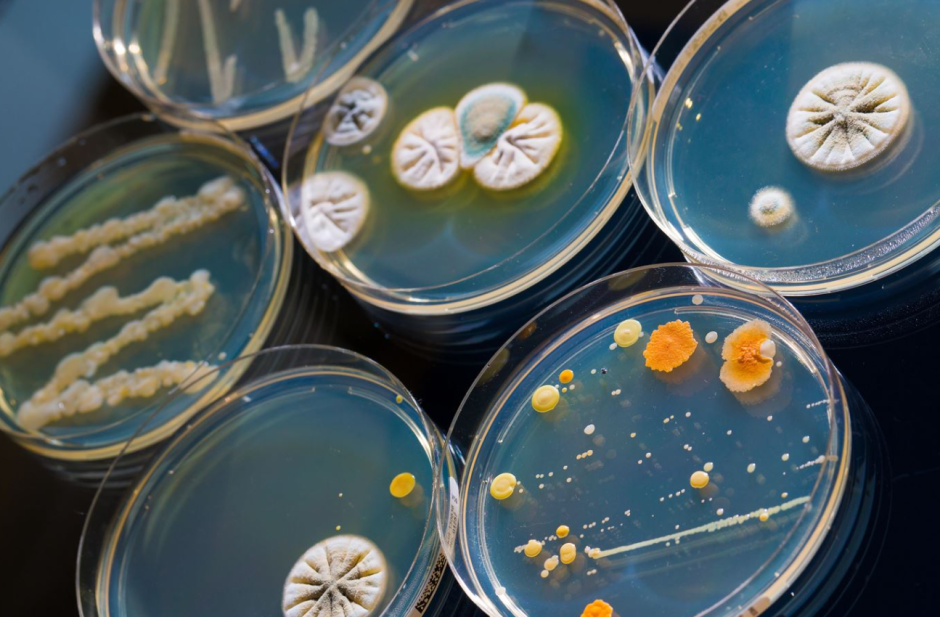
антибиотики, чашки петри антибиотики, чашки петри

6 августа 1881 года родился человек, который случайно совершил одно из величайших открытий в медицине. Александр Флеминг, скромный шотландский бактериолог, не любил убираться в лаборатории. И, как оказалось, это было к лучшему.

Плесень против бактерий: счастливая случайность
В 1928 году Флеминг исследовал стафилококки – бактерии, вызывающие гнойные инфекции. Вернувшись из отпуска, он обнаружил, что одна из чашек Петри с бактериями покрылась плесенью. Вместо того чтобы выбросить “испорченный” образец, ученый заметил нечто удивительное: вокруг плесени бактерии погибли.
Кабинет Александра Флеминга
Так был открыт пенициллин – первый в мире антибиотик, выделенный из обычной плесени Penicillium notatum. Правда, сам Флеминг не сразу осознал масштаб своего открытия. Он опубликовал статью, но вещество было нестабильным, и выделить его в чистом виде он не смог. Лишь спустя 10 лет фармаколог Говард Флори и биохимик Эрнст Чейн довели дело до конца, создав лекарство, которое спасло миллионы жизней во время Второй мировой войны.
Почему пенициллин стал революцией?
До открытия Флеминга даже небольшая царапина могла стать смертельной. Бактериальные инфекции – пневмония, сепсис, сифилис – убивали людей тысячами. Хирургические операции часто заканчивались заражением крови, а роды были опасны и для матери, и для ребенка.
Пенициллин изменил всё. В 1940-х годах он помог резко снизить смертность от инфекций, а в 1950-х антибиотики стали массово применяться в медицине. Казалось, человечество победило бактериальные болезни. Но, как выяснилось, ненадолго.
Темная сторона антибиотиков: почему ученые бьют тревогу
Сначала пенициллин работал почти против всех бактерий. Но чем чаще его использовали, тем больше микробы приспосабливались. Сегодня многие штаммы стали устойчивыми к антибиотикам, и врачам приходится искать новые препараты.
Проблема в том, что:
-
Антибиотики часто принимают без необходимости – например, при вирусных инфекциях (грипп, простуда), где они бесполезны.
-
Люди не всегда пьют лекарство полным курсом, давая бактериям шанс выжить и выработать защиту.
-
Антибиотики используют в животноводстве, из-за чего резистентные бактерии попадают в пищу.
Ученые предупреждают: если ситуация не изменится, к 2050 году устойчивые к антибиотикам инфекции могут убивать до 10 миллионов человек в год.
Что дальше?
Флеминг, кстати, предвидел эту проблему еще в 1945 году, когда получил Нобелевскую премию. В своей речи он предупредил, что бездумное использование пенициллина приведет к появлению супербактерий.
Александр Флеминг на вручении Нобелевской премии
Сейчас исследователи ищут новые способы борьбы с инфекциями: от бактериофагов (вирусов, убивающих бактерий) до генного редактирования. Но пока лучшая защита – разумное использование антибиотиков.
Так что в следующий раз, когда врач откажется выписывать вам антибиотик “на всякий случай”, не возмущайтесь – возможно, он спасает будущее человечества.
А Александру Флемингу стоит сказать спасибо не только за открытие, но и за своевременное предупреждение. И, конечно, за то, что он не любил убираться в лаборатории.